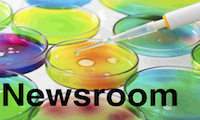

About Us
The Program in Microbiology and Molecular Genetics (MMG) provides training in the study of microorganisms as well as in the use of microbial models to investigate basic problems in molecular genetics. Research training is offered in bacterial genetics and physiology, microbial development, molecular biology of viruses and bacterial pathogens, mechanisms of bacterial and viral pathogenesis, molecular biology of gene regulation, antibiotic resistance, antiviral and vaccine development.
The MMG faculty is dedicated to training students in basic principles in microbiology so that graduates will have an outstanding foundation as they continue their career in science. Faculty are drawn from departments within the School of Medicine (Microbiology and Immunology, Medicine, Pathology and Pediatrics), School of Public Health, Emory College, The Centers for Disease Control and Prevention and the VA Medical Center. The faculty collaborate on contemporary microbiologic problems of interest that impact human health. The faculty is well-funded with extramural grant support from federal agencies such as the National Institutes of Health, National Science Foundation, and Veteran Administrations. The Emory Vaccine Center (faculty member Rafi Ahmed is the Director) and Center of Excellence for Influenza Research and Response Center provide unique training opportunities for MMG students.
Most of the MMG faculty have dual appointments and actively participate in other GDBBS graduate programs, including Genetics and Molecular Biology (GMB), Immunology and Molecular Pathogenesis (IMP), and Population Biology, Evolution and Ecology (PBEE). Such dual appointments enhance the opportunity for collaborations and increase the exposure of students to different aspects of contemporary issues in microbiology, biology and medicine.
Opportunities for dissertation research are grouped into two broad areas:
Molecular biology, physiology and genetics of microorganisms: Major topics in this area include mechanisms of transcriptional control in bacteria and viruses, regulation and physiology of developmental and differentiation processes, transport systems, metabolism, and genetics of antimicrobial production and resistance.
Microbial pathogenesis field: The important areas of research include the study of genes required for bacterial and viral virulence, action of virulence factors, and mechanisms of microbial escape from host defenses. Organisms studied include important viral pathogens such as the human immunodeficiency virus, adenoviruses, herpes viruses, influenzae virus, as well as bacterial pathogens such as streptococci, staphylococci, mycobacteria, enteropathogenic bacteria, bacteria that cause meningitis, and bacteria that cause sexually transmitted infections or urinary tract infections.
The objective of our graduate program is to train students to be successful independent investigators in biomolecular research. Our coursework focuses on this by emphasizing three main skills. First, we help our students learn the language of microbiology, biochemistry, molecular biology and molecular genetics. Second, we help our students learn to read the original literature and interpret it critically. Our goal is to enable our students to construct hypotheses and to design experiments to test these hypotheses. And third, we emphasize training in effective communication, both oral and written.
All scientists are involved in some form of teaching - either formal didactic education of others or presenting work to groups of peers or laymen. Therefore, training in teaching is valuable for all. Emory's Laney Graduate School requires a program for teacher training that has three components. First, there is a three-day summer workshop (TATTO = Teaching Assistant Training and Teaching Opportunities) TATTO 600, which provides information on teaching techniques, including design of audiovisual aids. Our students take this course in August, after the First Year. Second, the one-semester teaching assistant, TATTO 605, component is fulfilled by our students helping with an undergraduate or graduate course by leading in-class discussions and review sessions. Additional opportunities in teaching exist at the University including open workshops and seminars on teaching approaches, a Science Education Research Journal Club, TATTO Sustainability Fellowships, outreach activities with the Center for Science Education, and the Dean Teaching Fellowship.
The Qualifying Examination Committee consists of the Thesis Committee plus the Director of Graduate Studies. For students in the lab of the DGS, the alternate DGS will serve on the committee.
Written examination: By the end of May in the second year, students are expected to have passed an examination based on a research proposal, which might serve for their thesis work. The primary purpose of this examination is to give the students the opportunity to develop an original and significant scientific proposal and to defend it before a group of scientists who have relevant expertise. The examination is used as a teaching device and is one of the methods used to follow a student's academic progress. Recommendations for improving a student's progress are expected to result from each examination.
- By March 15 of the second year, the student must submit a 200-300 word written abstract that concisely states the problem, an original testable hypothesis, and an outline of experiments to test the hypothesis. A specific goal of this exercise is to train students to think concisely and to write meaningful short abstracts.
- The student is responsible for organizing the examination date with the committee and the DGS (generally late April or May). The full research proposal (see the section below regarding developing your proposal) should be submitted to the examining committee and DGS at least 2 weeks prior the oral examination. Please contact the Program Administrator for assistance in obtaining a room for the exam.
Immediately after the oral exam, the committee evaluates the student's performance, determines whether a need exists to retake an additional exam and makes written recommendations pertaining to future training. Students are also encouraged to speak with the faculty examiners after receiving their written comments.
Most students in the program complete the requirements for their degree in a little over 5 years.